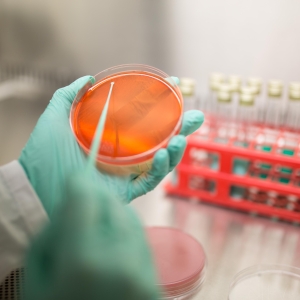

Lucrează cu noi
Lucrează cu noi
În compania Transavia grija și respectul pentru angajații noștri sunt principii de bază. Considerăm că de 30 de ani suntem o mare familie, ghidată de o serie de principii și valori comune.
Dacă ești în căutarea unui loc de muncă unde să îți poți valorifica experiența și cunoștințele sau te afli la începutul carierei, dar ești motivat să înveți și să te adaptezi unui mediu de lucru profesionist, te așteptăm în echipa noastră pentru a scrie mai departe povestea de succes Transavia.

Mesajul Conducerii

Compania Transavia se bucură de o reputație atât la nivel național, dar și internațional, ca urmare a rezultatelor excelente din cei 30 de ani de activitate de până în prezent. Fiecare angajat este conștient că succesul este asigurat dacă își desfășoară activitatea cu responsabilitate, disciplină și perseverență, este deschis și competitiv.
În relațiile profesionale și personale manifestăm respect, considerație și încredere; nu vom renunța să fim onești, politicoși și serioși pentru a construi relații durabile.
Principiile noastre de lucru au fost explicate întregii echipe Transavia. Împreună ne propunem să promovăm un mediu de lucru profesionist și competitiv, să protejăm mediul, bunăstarea animalelor și să ne menținem în topul angajatorilor români prin condițiile de muncă oferite și pachetul salarial. În prezent avem 2000 de angajati în 8 judeţe din România şi suntem într-o continuă dezvoltare.
Principiile și normele de conduită profesională și etică reflectă misiunea, valorile și idealurile pe care ne angajăm să le respectăm permanent.
Sunt convins că împreună vom contribui la păstrarea poziției de lider a companiei Transavia și vom menține un mediu de lucru profesionist, curat, etic și în care suntem mândri să ne desfășurăm activitatea.
Locuri de muncă
Compania noastră oferă locuri de muncă în fermele și fabricile din cele 8 județe în care suntem prezenți. Dacă sunteți interesați de unul dintre posturile disponibile, așteptăm CV-urile dumneavoastră.

Programul de training pentru studenți
Programul de training pentru studenți
Transavia are în prezent un acord de colaborare cu Universitatea de Științe Agricole și Medicină Veterinară Cluj-Napoca, Facultatea de Știință și Tehnologia Alimentelor și oferă studenților posibilitatea de a efectua stagii sau vizite de practică tehnologică în cadrul companiei noastre.
Pentru noi este importantă colaborarea cu studenții interesați de domeniul Agriculturii și al Zootehniei, deoarece putem oferi acestora un mediu de lucru profesionist, unde își vor putea pune în practică cunoștințele dobândite în anii de studiu și de asemenea, unde vor avea ocazia de a evolua profesional.
La Transavia, spiritul de ințiativă, proactivitatea și dorința de a învăța sunt apreciate și de fiecare dată oferim suportul nostru celor care își doresc să ajungă la performanță.

Programe de formare profesională
Programe de formare profesională
Pentru noi, pregătirea angajaților și familiarizarea acestora cu modelul integrat de lucru ce stă la baza activității noastre sunt extrem de importante pentru a ajunge rezultatele pe care ni le dorim.
De aceea, organizăm în mod constant programe de formare și instruire profesională pentru o integrare cât mai facilă a noilor angajați, dar și pentru a fi la curent cu cele mai recente și mai performante tehnologii din industria în care activăm.
Dacă ești interesat să lucrezi în compania noastră trebuie să știi că pentru succesul activității tale profesionale vei participa la cursuri de inițiere pentru a cunoaște valorile noastre, normele de conduită și etică profesională și regulile interne pe care trebuie să le respectăm împreună, pentru a continua să fim liderul pieței locale de carne de pui și unul dintre angajatorii de top din România.
Noi credem că pentru a atinge standarde din ce în ce mai înalte trebuie să fim responsabili, harnici, devotați și implicați în procesele de muncă și ne vom preocupa să existe o comunicare cât mai bună și un mod de lucru eficient alături de echipa din care faci parte.
